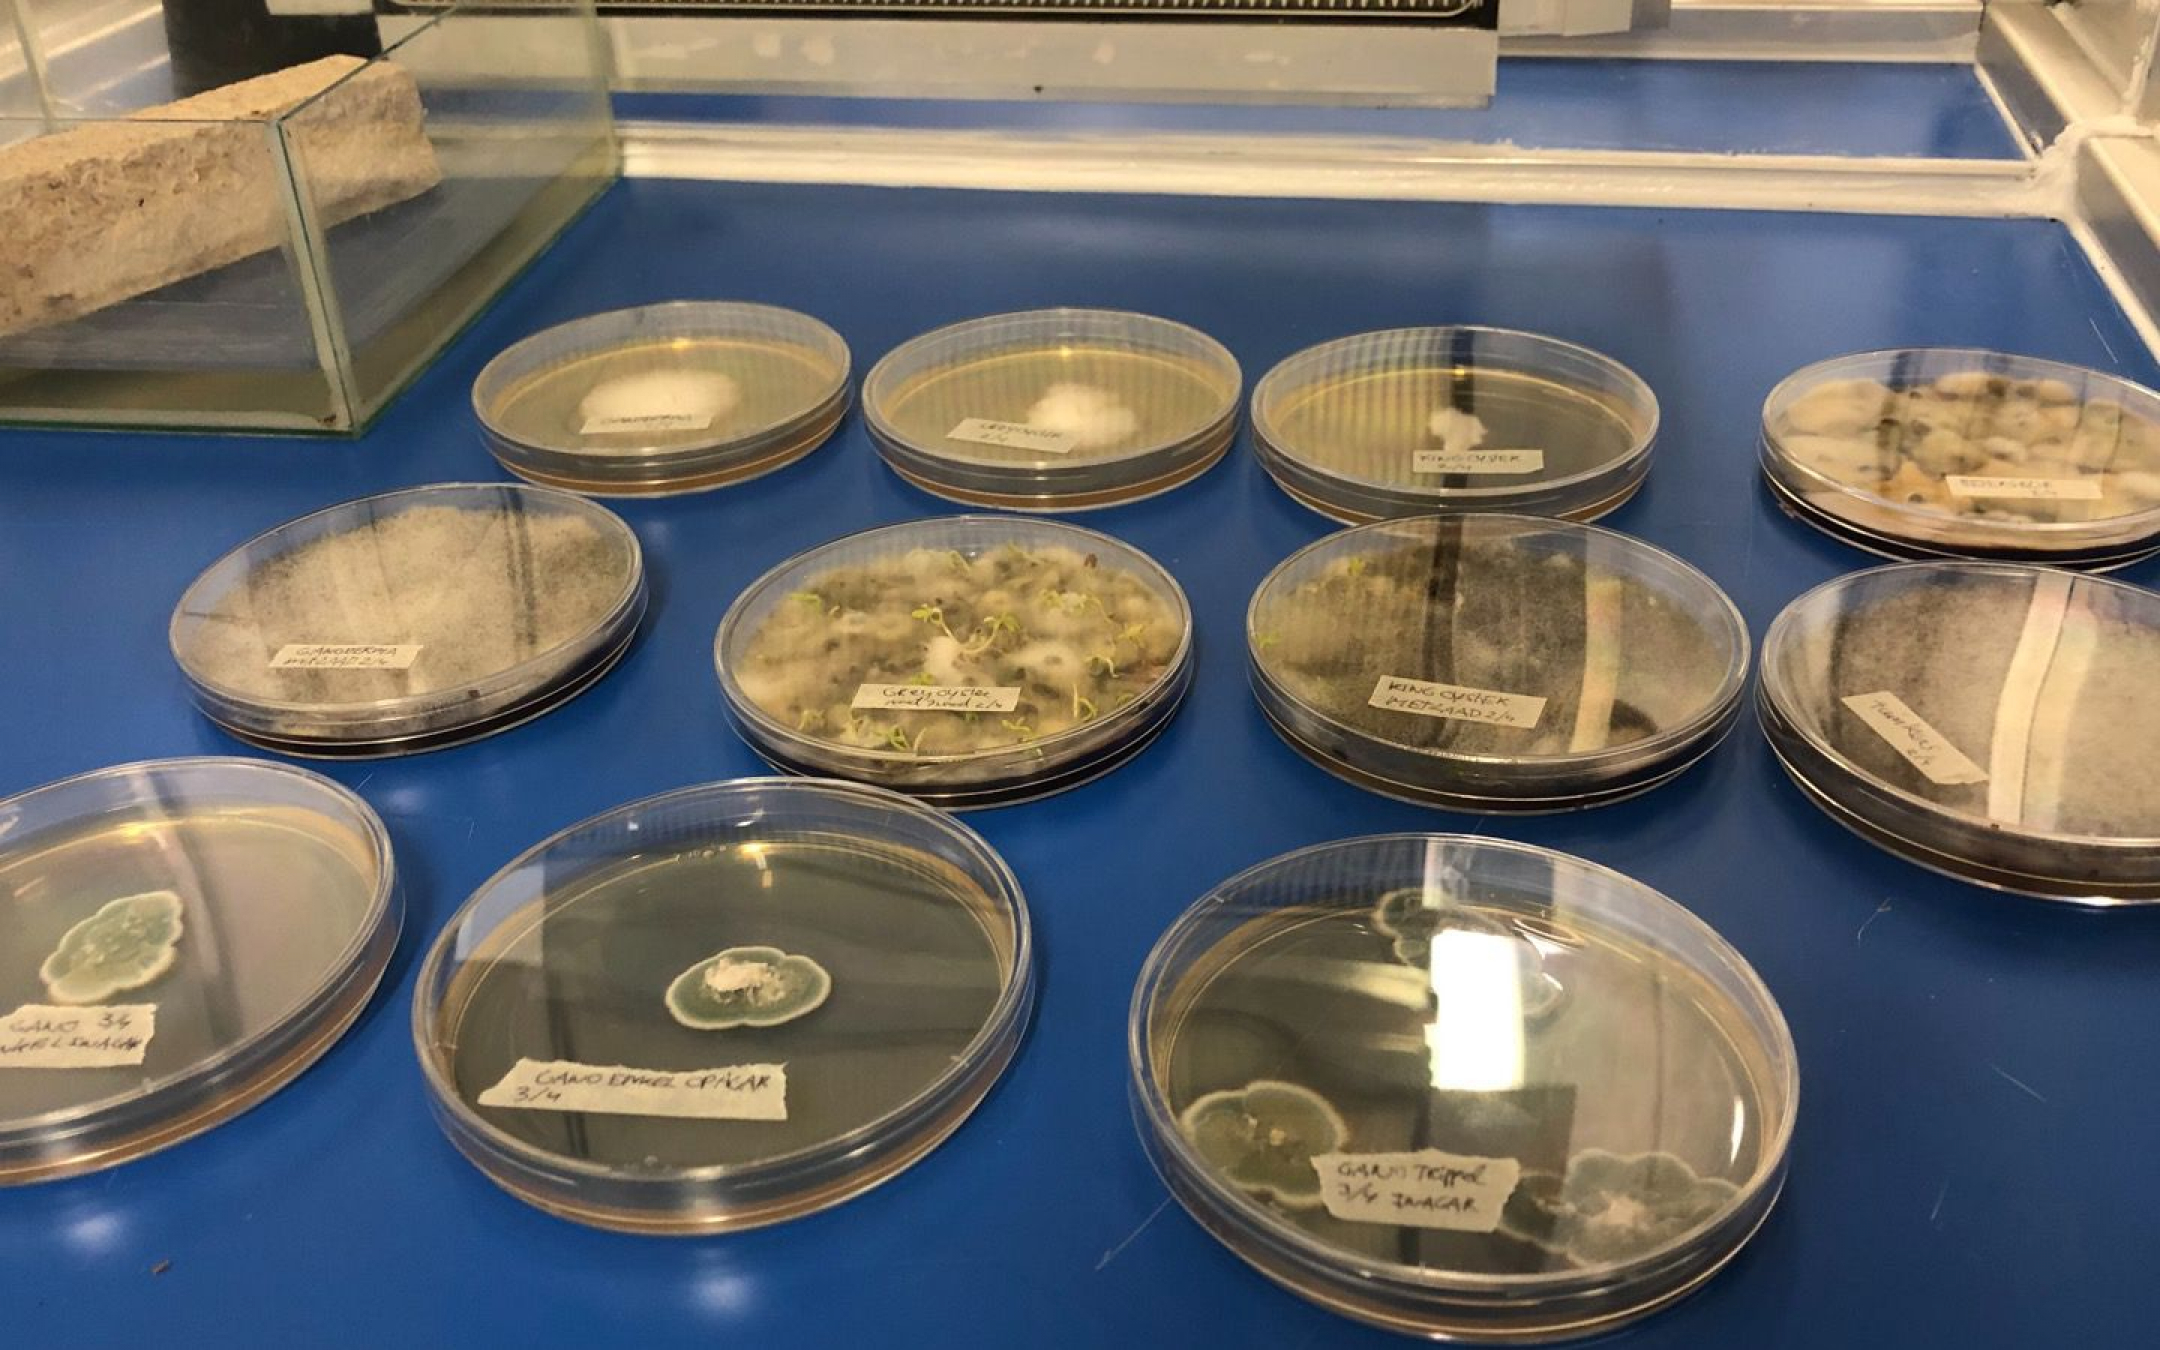
Living Coffin

Living Coffin Netherlands
World's first Living Coffin that feeds the Earth
The world's first Living Coffin enables humans to no longer pollute the earth, but allows humanity to enrich life after death. The coffin is made from mushrooms that are able to recycle toxins from the body & soil into plant food allowing new nature to thrive.
Company/Institution: Loop Biotech